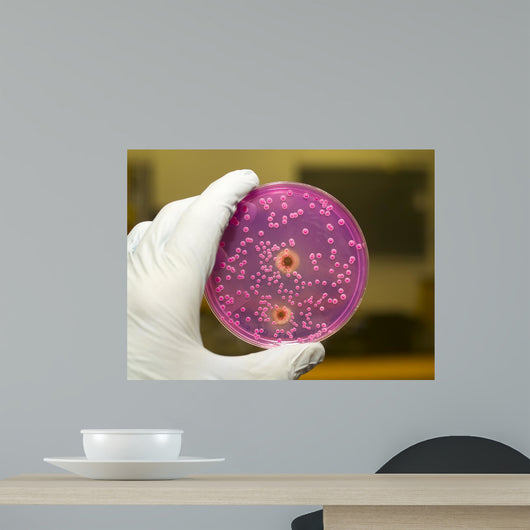
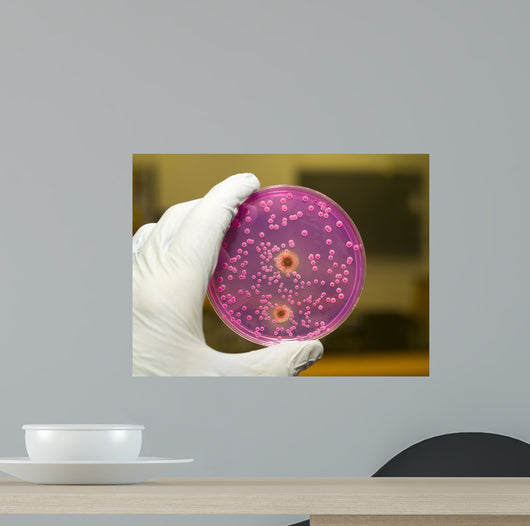
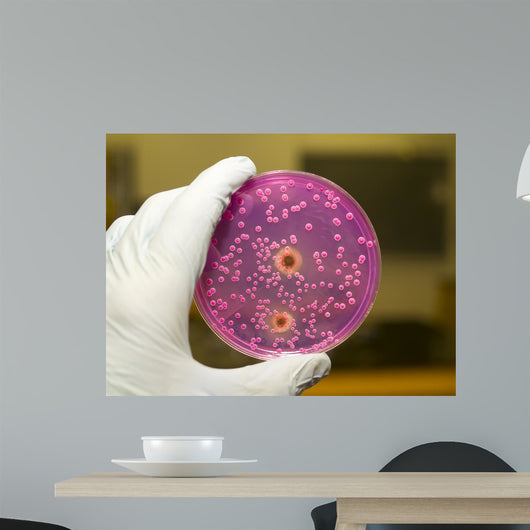
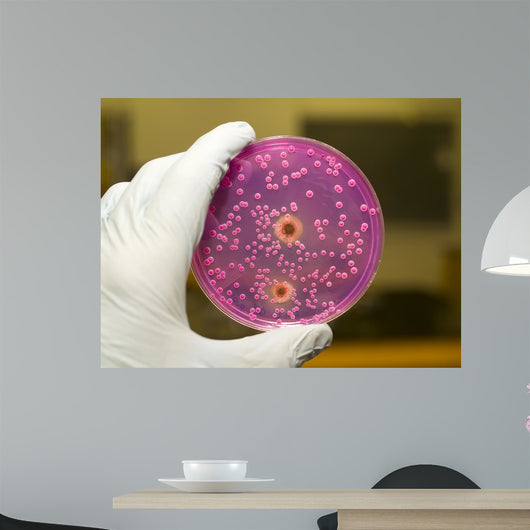
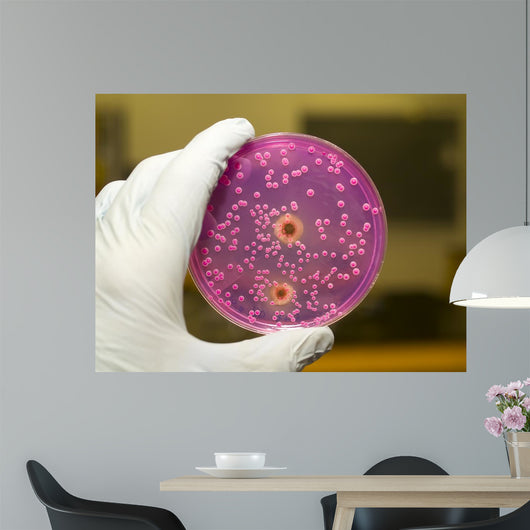
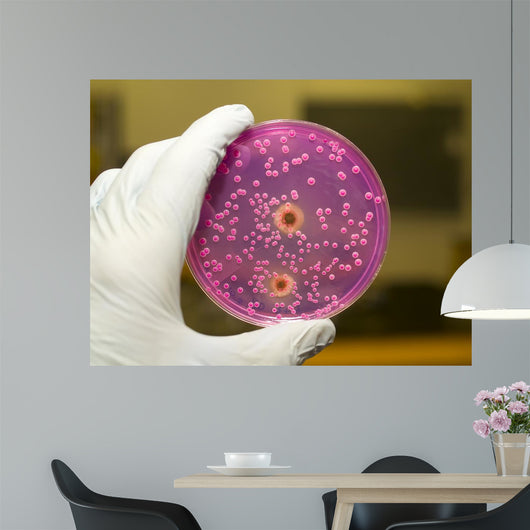
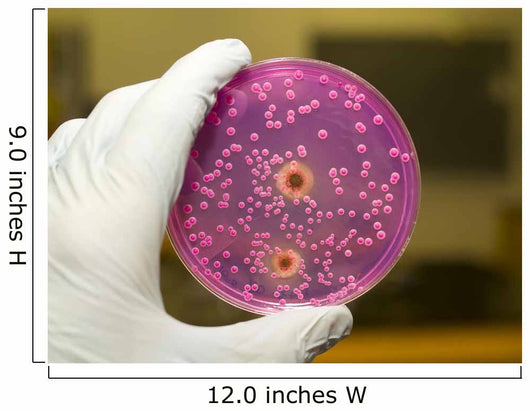

Yeast and Molds Wall Decal
SKU# DEP-8393020-18
Material Properties
Vinyl
• Semi-gloss
• Removable
• White opaque material (not translucent)
• Self-adhesive backing
Vinyl will stick to nearly any interior smooth surface including walls, glass, floors, windows and more!
Note: If you are a longtime fan of WallMonkeys, you may be looking for our previous Photo-Tex adhesive. Vinyl is our new default material, we believe it is a better fit for your walls. You may request Photo-Tex for rectangle and square-cut wall murals in the notes section at checkout.
• Semi-gloss
• Removable
• White opaque material (not translucent)
• Self-adhesive backing
Vinyl will stick to nearly any interior smooth surface including walls, glass, floors, windows and more!
Note: If you are a longtime fan of WallMonkeys, you may be looking for our previous Photo-Tex adhesive. Vinyl is our new default material, we believe it is a better fit for your walls. You may request Photo-Tex for rectangle and square-cut wall murals in the notes section at checkout.
Production Times
All orders are printed and shipped within 1-3 business days. Proofs are available within 1 business day from placing your order.
If your order requires a proof, production may be delayed while adjustments are made.
*Rush production is available upon request. View rush production FAQs here.
If your order requires a proof, production may be delayed while adjustments are made.
*Rush production is available upon request. View rush production FAQs here.
Installation
See detailed instructions here.
1. Leave decal unrolled and laying flat (overnight for sizes 36" and larger).
2. Clean your surface with a dry cloth to remove any dust or chemicals.
3. Carefully remove decal from backing paper. Extra hands are recommended for sizes 36" and above.
4. Firmly smooth the surface of your decal to the wall by starting at the center and pushing outwards. Remove and reapply corners to release air bubbles.
FAQs
Can you use WallMonkeys decals outside?
- No, Vinyl is designed for indoor use only.
Will the white background be removed?
- Yes, any all-white background will peel away when the decal is placed on the wall. More intricate designs may require a small white border for easier application.
Can I customize my decal?
- Yes, all orders are printed on-demand. We offer custom sizes and mirror-image adjustments at no charge. Simply add a note to your order at checkout.
Can I see a preview of my order before it prints?
- Yes, a digital proof is available within 1 business day on request. Request one in the notes section at checkout.
See more FAQs here.